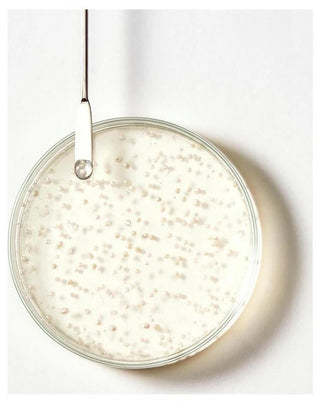

Le shampooing traitant antichute Triphasic réduit la chute de cheveux sans agresser le cuir chevelu. Sa formule sans silicone associe la vitamine B5, les extraits naturels de Pfaffia bio et de ginseng qui contribue à tonifier le cuir chevelu, et aux pouvoirs stimulants des biosphères d'huiles essentielles pour freiner la chute et favoriser la pousse de cheveux plus denses, plus épais. La texture transparente du produit laisse apparaître ces biosphères blanches et nacrées, qui éclatent délicatement sous les doigts au moment du shampoing. Nettoyés en douceur et plus résistants, les cheveux sont faciles à démêler, doux et brillants. 96% d'ingrédients d'origine naturelle. Sans silicone, sans tensio-actifs sulfatés. Formule biodégradable*. *selon OCDE301B. Son green impact index est a, on vous explique pourquoi. Le green impact index mesure l'impact environnemental et sociétal de nos produits à partir d'une note globale intégrant 20 critères. Le green impact index ne mesure pas l'efficacité du produit, ni ses effets sur la santé de chacun, mais son respect de la nature et de la société dans son ensemble (éco-socio-conception). Chez pierre Fabre, on estime qu'un produit commence à être éco-socio-conçu à partir d'une note b, même si l'objectif est à terme d'atteindre a. L'impact environnemental et sociétal de ce produit est : emballage comportant au moins 36% de matières recycléesEmballage non recyclable formule d'origine naturelle 96%***** fabriqué dans une usine certifiée pour l'environnement***plante issue de l'agriculture biologique ***selon la norme ISO 14001 ou ECOVADIS - action ANTI chute : stimule le cuir chevelu et préserve le capital cheveux - aide à la croissance de cheveux plus forts : lave en douceur et favorise une pousse de cheveux plus épais et plus sains. - texture sensorielle : enveloppe la chevelure d'un parfum frais et végétal telle une invitation au massage, les biosphères blanches et nacrées d'huiles essentielles éclatent délicatement sous les doigts à l'émulsion pour libérer leurs précieux pouvoirs directement sur le cuir chevelu.
Le shampooing traitant antichute Triphasic réduit la chute de cheveux sans agresser le cuir chevelu. Sa formule sans silicone associe la vitamine B5, les extraits naturels de Pfaffia bio et de ginseng qui contribue à tonifier le cuir chevelu, et aux pouvoirs stimulants des biosphères d'huiles essentielles pour freiner la chute et favoriser la pousse de cheveux plus denses, plus épais. La texture transparente du produit laisse apparaître ces biosphères blanches et nacrées, qui éclatent délicatement sous les doigts au moment du shampoing. Nettoyés en douceur et plus résistants, les cheveux sont faciles à démêler, doux et brillants. 96% d'ingrédients d'origine naturelle. Sans silicone, sans tensio-actifs sulfatés. Formule biodégradable*. *selon OCDE301B. Son green impact index est a, on vous explique pourquoi. Le green impact index mesure l'impact environnemental et sociétal de nos produits à partir d'une note globale intégrant 20 critères. Le green impact index ne mesure pas l'efficacité du produit, ni ses effets sur la santé de chacun, mais son respect de la nature et de la société dans son ensemble (éco-socio-conception). Chez pierre Fabre, on estime qu'un produit commence à être éco-socio-conçu à partir d'une note b, même si l'objectif est à terme d'atteindre a. L'impact environnemental et sociétal de ce produit est : emballage comportant au moins 36% de matières recycléesEmballage non recyclable formule d'origine naturelle 96%***** fabriqué dans une usine certifiée pour l'environnement***plante issue de l'agriculture biologique ***selon la norme ISO 14001 ou ECOVADIS - action ANTI chute : stimule le cuir chevelu et préserve le capital cheveux - aide à la croissance de cheveux plus forts : lave en douceur et favorise une pousse de cheveux plus épais et plus sains. - texture sensorielle : enveloppe la chevelure d'un parfum frais et végétal telle une invitation au massage, les biosphères blanches et nacrées d'huiles essentielles éclatent délicatement sous les doigts à l'émulsion pour libérer leurs précieux pouvoirs directement sur le cuir chevelu.